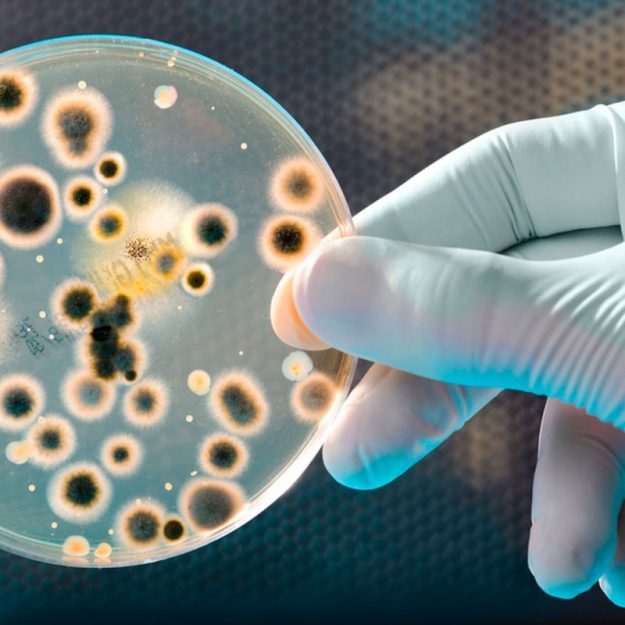
legionella kontrol

For at give dig de bedste oplevelser bruger vi teknologier som cookies til at gemme og/eller få adgang til enhedsoplysninger. Hvis du giver dit samtykke til disse teknologier, kan vi behandle data som f.eks. browsingadfærd eller unikke ID'er på dette websted. Hvis du ikke giver dit samtykke eller trækker dit samtykke tilbage, kan det have en negativ indvirkning på visse funktioner og egenskaber.
Den tekniske lagring eller adgang er strengt nødvendig med det legitime formål at muliggøre brugen af en specifik tjeneste, som abonnenten eller brugeren udtrykkeligt har anmodet om, eller udelukkende med det formål at overføre en kommunikation via et elektronisk kommunikationsnet.
Den tekniske lagring eller adgang er nødvendig for det legitime formål at lagre præferencer, som abonnenten eller brugeren ikke har anmodet om.
Den tekniske lagring eller adgang, der udelukkende anvendes til statistiske formål.
Den tekniske lagring eller adgang, der udelukkende anvendes til anonyme statistiske formål. Uden en stævning, frivillig overholdelse fra din internetudbyders side eller yderligere optegnelser fra en tredjepart kan oplysninger, der er gemt eller hentet til dette formål alene, normalt ikke bruges til at identificere dig.
Den tekniske lagring eller adgang er nødvendig for at oprette brugerprofiler med henblik på at sende reklamer eller for at spore brugeren på et websted eller på tværs af flere websteder med henblik på lignende markedsføringsformål.